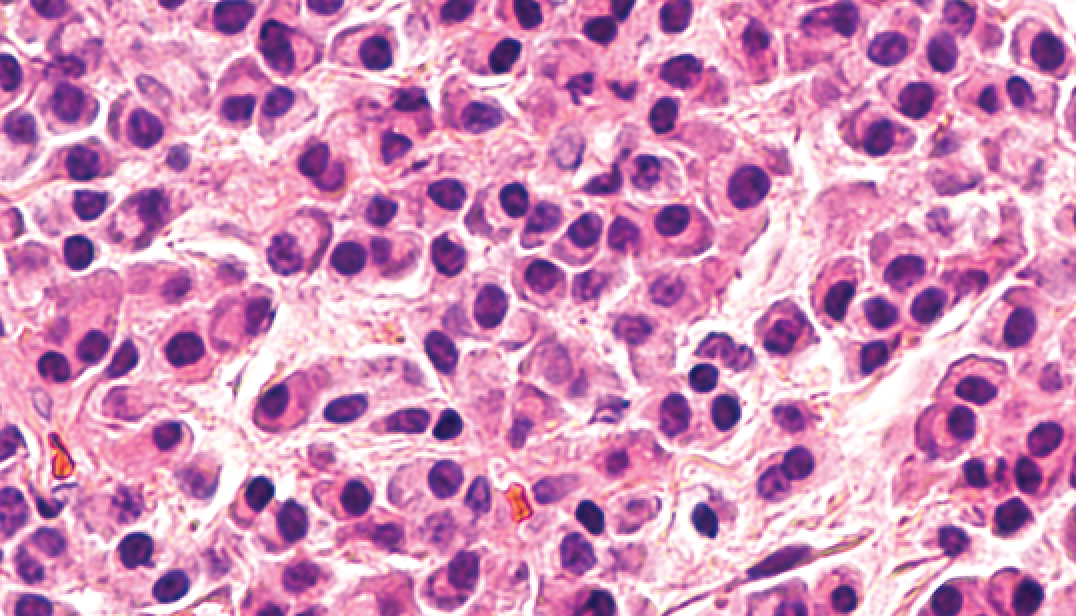

As treatments lead to deeper and more sustained responses, new markers for measuring and predicting treatment response that are more sensitive than current endpoints are required.
This page will explore minimal residual disease (MRD), which is currently being investigated as a potential surrogate endpoint for survival outcomes in clinical studies.
Despite achieving a complete response (CR) following induction therapy, some patients with multiple myeloma (MM) subsequently go on to relapse with poor outcomes – suggesting that some residual disease remains. This minimal residual disease is known as MRD.
New, sensitive methods for detecting MRD at a very low level are needed.
The MRD-negativity threshold defines undetectable disease. In the updated International Myeloma Working Group response criteria for MM, MRD negativity is defined as the absence of clonal plasma cells in bone marrow aspirates at a minimum sensitivity of 1 in 100,000 (105) nucleated cells or higher, in patients who have achieved a CR.
The MRD-negativity threshold is considerably more sensitive than the criteria for CR, which requires negative immunofixation in the urine and serum, disappearance of any soft tissue plasmacytomas and <5% plasma cells in bone marrow aspirates.
Imaging negative criteria provide a measure of disease outside of the bone marrow – requiring the disappearance of positive lesions seen on baseline or previous positron emission tomography/computed tomography (PET/CT) scans.
If MRD negativity can be shown both inside, using next-generation sequencing (NGS) or next-generation flow (NGF), and outside (using imaging) of the bone marrow, and can be confirmed by assessments at least one year apart, it is considered to be sustained.
MRD testing over time may provide the best assessment of a sustained response; however, the optimal timing and frequency of MRD evaluation is still under investigation.
To detect MRD at levels of one cell in 10⁵–10⁶, tests with high sensitivity and specificity are required.
NGS or NGF are recommended for the assessment of MRD in bone marrow aspirates at the minimum threshold of 1 in 105 cells. Flow cytometry is another commonly used technique for evaluating MRD in bone marrow samples.
Adapted from Kumar et al. 2016 and Paiva et al. 2015
Current MRD assessment techniques, such as NGS or NGF, analyse cells collected from bone marrow biopsy or aspirate. The procedures to obtain bone marrow biopsies and aspirations are painful for the patient and, as they are taken from a single site, may not reflect the heterogeneous nature of MM and result in false-negative results. Mass spectrometry analysis of M-protein as a way to measure MRD is being considered using peripheral blood samples, and in some cases bone marrow samples.
MRD negativity is predictive of long-term progression-free survival (PFS) and overall survival (OS).
Several meta-analyses have shown that overall, MRD-negative status is associated with significantly better PFS and OS compared with being MRD-positive.
Deeper responses mean better outcomes. Patients with CR who are also MRD-negative showed better PFS and OS compared with those who remained MRD-positive. The superiority of MRD negativity over CR is even seen in patients with high-risk cytogenetic abnormalities.
The assessment of MRD negativity is now being used in an increasing number of clinical trials as a primary or secondary endpoint.
Further clinical trials are being conducted to understand whether MRD-negative status can be used to assess treatment response and to guide treatment decisions in clinical practice.
Currently, an MRD consortium, the International Independent Team for Endpoint Approval of Myeloma MRD (i2 TEAMM), is developing a meta-analysis based on primary source data to be provided by investigators examining MRD in randomised Phase 3 trials. This meta-analysis will be submitted to the European Medicines Agency (EMA) and the US Food and Drug Administration (FDA) for the designation of MRD as a surrogate endpoint for PFS and OS.
There are a range of diagnostic methods that can generate an in-depth picture of the patient’s myeloma characteristics. Early detection is paramount in disease management and in determining a treatment plan.
Even with significant advances in treatment, myeloma remains a challenging disease. Find out more about this type of cancer and its pathophysiology.